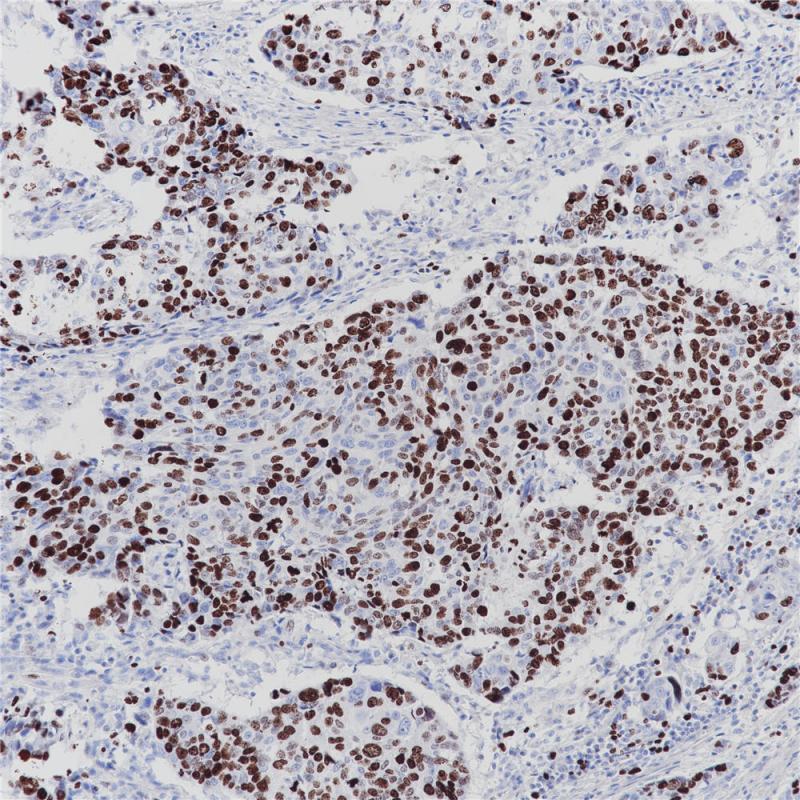
食道癌 Ki-67 (BP6132) 染色

产品中心

宫颈癌 Ki-67 (BP6132) 染色
食道癌 Ki-67 (BP6132) 染色

扁桃体 Ki-67 (BP6132) 染色
Ki-67 重组兔单克隆抗体
Ki-67抗原是一种与细胞增殖有关的核蛋白,可能是细胞增殖的关键因素。此外,Ki-67还与核糖体RNA转录有关。Ki-67存在于细胞分裂周期G1、S、M和G2期,但在细胞静止期G0期不表达。Ki-67被用作不同类型肿瘤的诊断工具,因为它存在于所有增殖细胞(正常细胞和肿瘤细胞)中,是一种用来确定给定细胞群体增殖比率非常好的标记物。
Specifications
- 目录号
- BX50204
- 克隆号
- BP6181
- 阳性对照
- 扁桃体
- 亚细胞定位
- 细胞核
- 组织类型
- FFPE
- 修复方式
- HIER
- 稀释比
- 1:100-1:200
- 规格
- 100μl/vial, 1ml/vial
- 用途
- RUO
Reference
1.Scholzen T, et.al, J Cell Physiol. 2000 Mar;182(3):311-22.
2.Inwald EC, et.al, Breast Cancer Res Treat. 2013 Jun;139(2):539-52.


